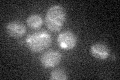
YHR011W
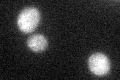
YHR011W

View description
Probable mitochondrial seryl-tRNA synthetase, mutant displays increased invasive and pseudohyphal growth
Localization:
Intensity:
Fold change:
Significance:
-
C’ GFP library in SD
mitochondria22.36 -
N' NOP1pr-GFP in SD

mitochondria50.3269 -
N' TEF2pr-mCherry in SD

mitochondria80.8178 -
N' NATIVEpr-GFP in SD

cytosol31.0689 -
N' TEF2pr-VC and Cyto-VN in SD

#N/A0 -
C’ GFP library in SD+DTT
mitochondria18.240.81Yes -
C’ GFP library in SD+H2O2

mitochondria20.340.9No -
C’ GFP library in Starvation Media

mitochondria19.780.88No -
C’ GFP library on the background of Pup2-DaMP

punctate -
C’ GFP library on the background of CCT mutant

mitochondriaN/AN/ANo
